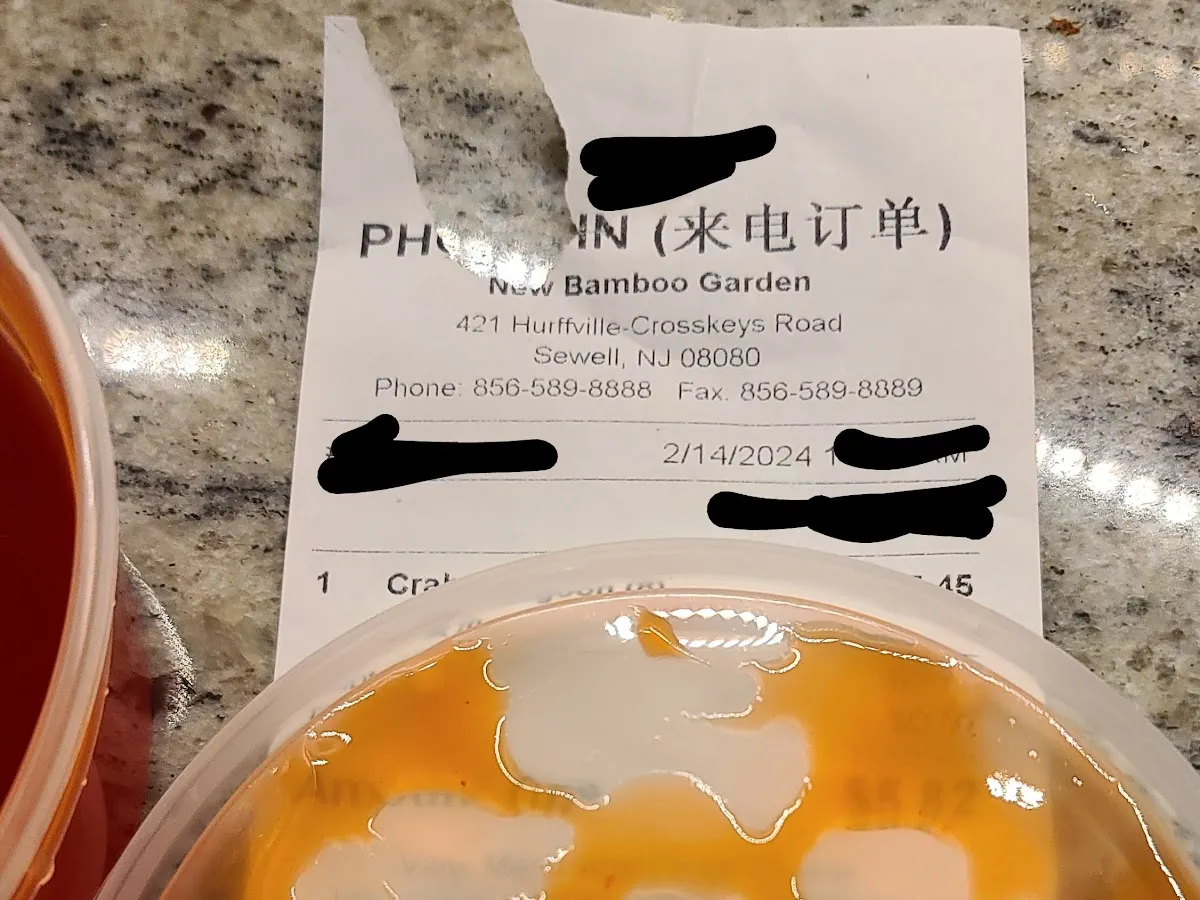

New Bamboo Garden
4.4
(202 reviews)Open now
Location & Hours
TueClosed
Wed11 AM–9:30 PM
Thu11 AM–9:30 PM
Fri11 AM–10:30 PM
Sat11 AM–10:30 PM
Sun12–9:30 PM
Reviews
202 total reviewsNo reviews yet. Be the first to review!
Write a Review
JerseyTopTen Score
67
Based on reviews, votes, and engagement
Ranked #8 of 76 in Camden


